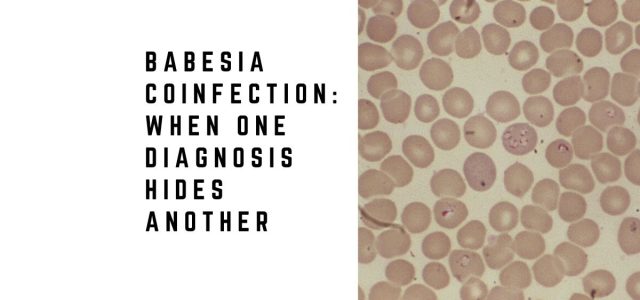
Babesia Coinfection: When One Diagnosis Hides Another

Lyme Disease Diagnosis Almost Missed in Patient With Babesia
Babesia and Lyme disease can occur together
Coinfections may complicate diagnosis and recovery
Missed cases may delay treatment and worsen outcomes
The importance of clinicians considering other tick-borne diseases, such as Babesia, when evaluating patients with Lyme disease has been addressed in the literature. Surprisingly, however, physicians may not consider Borrelia burgdorferi (the Lyme pathogen) as a coinfection in patients diagnosed with another tick-borne disease. Such was the case for an elderly man diagnosed with Babesia, who also had Lyme disease that was almost overlooked, according to a case report by Zaiem and colleagues.

The case report serves as a reminder to practitioners that as the number of reported cases of tick-transmitted diseases grows, Lyme disease should also remain on their radar as a coinfection.
One study by Dr. Brian Fallon and colleagues found Lyme disease was overlooked an average of 2 years in patients later diagnosed with Lyme encephalopathy [1] and in patients initially believed to have psychiatric illness. [2]
According to a case series by Dr. Daniel Cameron, some Lyme disease patients remained ill for years before diagnosis and eventually demonstrated serologic confirmation with positive IgG Western blot findings. [3]
- 34-year-old man with an EM rash who remained ill for 8 years;
- 16-year-old young woman with Epstein-Barr and strep infection who remained ill for 8 years;
- 57-year-old man with tick exposure and knee swelling who remained ill for 6 years;
- 16-year-old boy with Bell’s palsy who remained ill for 6 years;
- 35-year-old man told he did not have Lyme disease who remained ill for 3 years;
- 42-year-old woman with a negative spinal tap who remained ill for 3 years. [3]
A delayed Lyme disease diagnosis can be concerning because treatment delays have been associated with worse outcomes. Patients in Fallon’s study remained ill an average of 9 years after symptom onset. [1] Delayed patients in Cameron’s series were six times more likely to fail initial treatment. [3]
Borrelia as a Coinfection
“Co-infection with Borrelia should be considered in patients with atypical presentation or with a poor response to proper therapy,” concludes Zaiem. [4]
A case report published in QJM: An International Journal of Medicine describes a 70-year-old man presenting with headaches, high fevers, vomiting, and low urine output. Babesia was considered because of residence in Eastern Long Island, New York. Malaria was also considered because he had emigrated from Bangladesh six months earlier.
Laboratory testing supported Babesia. “Peripheral blood smear revealed intracellular ovoid rings resembling both Plasmodium sp. and B. microti rings,” states Zaiem. PCR confirmed B. microti. He was treated with doxycycline and quinine and improved clinically.
Just before discharge, the patient developed Bell’s palsy. Testing confirmed Lyme disease. The infection may have been missed had Bell’s palsy not developed—a symptom reported in only 9% of Lyme disease patients in CDC surveillance data. [4]
Illnesses transmitted by ticks can be complex. Follow-up evaluations remain important. Prior antibiotics, atypical symptoms, and incomplete histories may complicate diagnosis. [5-14]
Given evidence that ticks may carry more than one pathogen simultaneously, coinfections should remain in the differential diagnosis when one tick-borne illness is confirmed. A New York study found B. burgdorferi in 55% of sampled ticks, followed by A. phagocytophilum, B. microti, and E. chaffeensis. [15]
Lyme disease should remain under consideration in patients diagnosed with Babesia. [16-23] Krause and colleagues described increased illness severity when Babesia and Lyme disease occurred together. [24] Steere and colleagues reported more symptoms among coinfected patients. [25]
Coinfections and Treatment Outcome
An infection with more than one tick-borne disease can affect outcome. Krause concluded that physicians should evaluate for additional infections in Lyme disease patients with prolonged flu-like illness that fails to respond as expected. [26]
Transverse myelitis [27] and fatal pancarditis [28] illustrate how severe outcomes may occur in patients with both Lyme disease and Babesia.
Patients who fail to improve as expected may warrant reassessment for persistent Lyme disease symptoms and overlapping infections.
Frequently Asked Questions
Can Babesia and Lyme disease occur together?
Yes. Ticks may carry multiple pathogens simultaneously.
Can Babesia make Lyme disease worse?
Several studies suggest coinfection may increase symptom severity.
Can Lyme disease be missed if Babesia is diagnosed first?
Yes. Diagnosing one infection may delay recognition of another.
What symptoms suggest coinfection?
Persistent fever, chills, sweats, poor treatment response, or unusual severity may raise suspicion.
Why are follow-up visits important?
Symptoms evolve and additional diagnoses may emerge over time.
Clinical Takeaway
Babesia and Lyme disease frequently overlap clinically and geographically.
Missing one infection while diagnosing another may delay treatment, prolong illness, and complicate recovery.
Related Articles
Explore additional articles on overlapping infections and diagnosis:
Delayed Lyme disease diagnosis
Persistent Lyme disease mechanisms
Lyme disease misdiagnosis
Neurologic Lyme disease
Recovery from Lyme disease
References:
- Fallon BA, Keilp JG, Corbera KM et al. A randomized, placebo-controlled trial of repeated IV antibiotic therapy for Lyme encephalopathy. Neurology, 70(13), 992-1003 (2008).
- Fallon BA, Nields JA. Lyme disease: a neuropsychiatric illness. Am J Psychiatry, 151(11), 1571-1583 (1994).
- Cameron DJ. Consequences of treatment delay in Lyme disease. J Eval Clin Pract, 13(3), 470-472 (2007).
- Zaiem F, Alkawam H, Lee S, Fabisevich M. Severe Symptomatic Babesiosis Co-infection with Lyme Disease. QJM, (2015).
- Brunner M, Sigal LH. Use of serum immune complexes in a new test that accurately confirms early Lyme disease and active infection with Borrelia burgdorferi. J Clin Microbiol, 39(9), 3213-3221 (2001).
- Schutzer SE, Coyle PK, Belman AL, Golightly MG, Drulle J. Sequestration of antibody to Borrelia burgdorferi in immune complexes in seronegative Lyme disease. Lancet, 335(8685), 312-315 (1990).
- Singh SK, Girschick HJ. Lyme borreliosis: from infection to autoimmunity. Clin Microbiol Infect, 10(7), 598-614 (2004).
- Dattwyler RJ, Volkman DJ, Luft BJ, Halperin JJ, Thomas J, Golightly MG. Seronegative Lyme disease. Dissociation of specific T- and B-lymphocyte responses to Borrelia burgdorferi. N Engl J Med, 319(22), 1441-1446 (1988).
- Steere AC. Seronegative Lyme disease. JAMA, 270(11), 1369 (1993).
- Dressler F, Yoshinari NH, Steere AC. The T-cell proliferative assay in the diagnosis of Lyme disease. Ann Intern Med, 115(7), 533-539 (1991).
- Schutzer SE, Coyle PK, Reid P, Holland B. Borrelia burgdorferi-specific immune complexes in acute Lyme disease. JAMA, 282(20), 1942-1946 (1999).
- Brunner M. New method for detection of Borrelia burgdorferi antigen complexed to antibody in seronegative Lyme disease. J Immunol Methods, 249(1-2), 185-190 (2001).
- Kantor FS. Disarming Lyme disease. Sci Am, 271(3), 34-39 (1994).
- Ang CW, Notermans DW, Hommes M, Simoons-Smit AM, Herremans T. Large differences between test strategies for the detection of anti-Borrelia antibodies are revealed by comparing eight ELISAs and five immunoblots. Eur J Clin Microbiol Infect Dis (2011).
- Aliota MT, Dupuis AP 2nd, Wilczek MP, Peters RJ, Ostfeld RS, Kramer LD. The prevalence of zoonotic tick-borne pathogens in Ixodes scapularis collected in the Hudson Valley, New York State. Vector Borne Zoonotic Dis, 14(4), 245-250 (2014).
- dos Santos CC, Kain KC. Two tick-borne diseases in one: a case report of concurrent babesiosis and Lyme disease in Ontario. CMAJ, 160(13), 1851-1853 (1999).
- Swanson SJ, Neitzel D, Reed KD, Belongia EA. Coinfections acquired from Ixodes ticks. Clin Microbiol Rev, 19(4), 708-727 (2006).
- Thompson C, Spielman A, Krause PJ. Coinfecting deer-associated zoonoses: Lyme disease, babesiosis, and ehrlichiosis. Clin Infect Dis, 33(5), 676-685 (2001).
- Hunfeld KP, Hildebrandt A, Gray JS. Babesiosis: recent insights into an ancient disease. Int J Parasitol, 38(11), 1219-1237 (2008).
- Aguero-Rosenfeld ME. Laboratory aspects of tick-borne diseases: Lyme, human granulocytic ehrlichiosis and babesiosis. Mt Sinai J Med, 70(3), 197-206 (2003).
- Lotric-Furlan S, Ruzic-Sabljic E, Strle F. Concomitant human granulocytic anaplasmosis and Lyme neuroborreliosis. Clin Microbiol Infect, 15 Suppl 2, 28-29 (2009).
- Doudier B, Olano J, Parola P, Brouqui P. Factors contributing to emergence of Ehrlichia and Anaplasma spp. as human pathogens. Vet Parasitol, 167(2-4), 149-154 (2010).
- Wakeel A, Zhu B, Yu XJ, McBride JW. New insights into molecular Ehrlichia chaffeensis-host interactions. Microbes Infect, 12(5), 337-345 (2010).
- Krause PJ, Telford SR 3rd, Spielman A et al. Concurrent Lyme disease and babesiosis. Evidence for increased severity and duration of illness. JAMA, 275(21), 1657-1660 (1996).
- Steere AC, Dhar A, Hernandez J et al. Systemic symptoms without erythema migrans as the presenting picture of early Lyme disease. Am J Med, 114(1), 58-62 (2003).
- Krause PJ, McKay K, Thompson CA et al. Disease-specific diagnosis of coinfecting tickborne zoonoses: babesiosis, human granulocytic ehrlichiosis, and Lyme disease. Clin Infect Dis, 34(9), 1184-1191 (2002).
- Oleson CV, Sivalingam JJ, O’Neill BJ, Staas WE Jr. Transverse myelitis secondary to coexistent Lyme disease and babesiosis. J Spinal Cord Med, 26(2), 168-171 (2003).
- Marcus LC, Steere AC, Duray PH, Anderson AE, Mahoney EB. Fatal pancarditis in a patient with coexistent Lyme disease and babesiosis. Demonstration of spirochetes in the myocardium. Ann Intern Med, 103(3), 374-376 (1985).
Dr. Daniel Cameron, MD, MPH
Lyme disease clinician with over 30 years of experience and past president of ILADS.
Symptoms • Testing • Coinfections • Recovery • Pediatric • Prevention


